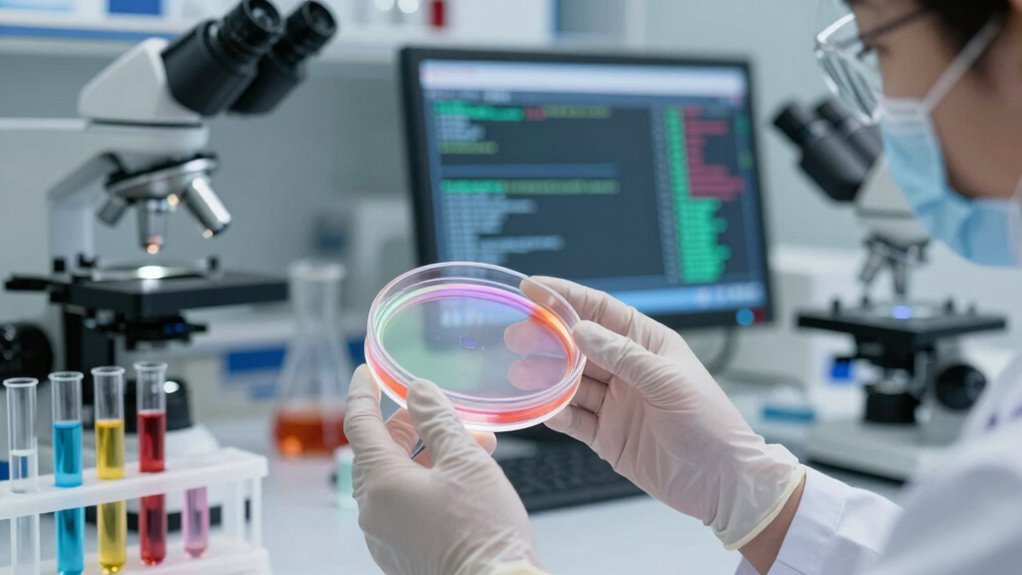

Antibiotic resistance is spreading fast, but you can slow it down by practicing responsible use, like only taking antibiotics when needed, following your healthcare provider’s instructions. Improving hygiene, staying up-to-date with vaccines, and supporting policies aimed at controlling misuse are essential. Innovations like rapid diagnostics and new treatments also help. If you stay informed, you’ll find effective ways to combat resistance and protect health for everyone.
Key Takeaways
- Responsible antibiotic prescribing and adherence to guidelines prevent unnecessary use and slow resistance development.
- Vaccination reduces infection rates, decreasing the need for antibiotics and limiting resistance spread.
- Good hygiene practices and surface disinfection limit bacterial transmission and reduce selective pressure for resistant strains.
- Promoting microbial diversity through diet and natural tools enhances microbiome resilience against resistant bacteria.
- Global policies, surveillance, and cross-border cooperation are essential for coordinated resistance containment efforts.
![Easy@Home Vaginal pH Test Strips: [5 Pack] Yeast Infection & BV (Bacterial Vaginosis) Testing Kit for Women with Swabs, Feminine pH Balance Health Tests, at Home pH Level Tester #EVPH-S](https://m.media-amazon.com/images/I/41cQ0r2hDAL._SL500_.jpg)
Easy@Home Vaginal pH Test Strips: [5 Pack] Yeast Infection & BV (Bacterial Vaginosis) Testing Kit for Women with Swabs, Feminine pH Balance Health Tests, at Home pH Level Tester #EVPH-S
Test to Identify – Quickly check vaginal pH levels to detect acidity or alkalinity, helping identify early signs…
As an affiliate, we earn on qualifying purchases.
As an affiliate, we earn on qualifying purchases.
What Is Antibiotic Resistance and Why Does It Matter?

Have you ever wondered why some infections become harder to treat over time? It all comes down to microbial evolution, where bacteria adapt to survive antibiotics. When you use antibiotics improperly or excessively, you give bacteria a chance to develop resistance. This means they can withstand medications designed to kill them, making infections more difficult to treat. That’s why antibiotic stewardship is so crucial—it’s about using antibiotics wisely to slow down this process. By reducing unnecessary prescriptions and completing prescribed courses, you help prevent bacteria from evolving resistance. Essentially, antibiotic resistance occurs when bacteria change in ways that protect them from drugs meant to eliminate them. This evolution threatens current treatments and puts public health at risk, making it vital to understand and combat it effectively. Additionally, advancements in technology and future trends in advertising can be leveraged to promote awareness and education about responsible antibiotic use. Promoting public health initiatives can further support efforts to combat resistance at a community and global level. Addressing antimicrobial stewardship programs is essential for developing sustainable solutions to this growing threat. Understanding the genetic mechanisms behind resistance can help in designing targeted strategies to counteract resistant bacteria. Moreover, ongoing research into bacterial mutation rates provides insights into how quickly resistance can develop and spread.

The Pharmacist's Guide to Antimicrobial Therapy and Stewardship
As an affiliate, we earn on qualifying purchases.
As an affiliate, we earn on qualifying purchases.
How Do Antibiotics Contribute to Resistance?

When you use antibiotics, you can disrupt the natural balance of microbes in your body, making it easier for resistant strains to develop. These medications also create an environment where resistant bacteria thrive and spread. Understanding this process helps explain how antibiotic use can unintentionally fuel resistance. Proper use of antibiotics, along with preventative measures, can help slow down the development of resistance.
Disrupts Microbial Balance
Antibiotics can unintentionally disturb the delicate balance of your body’s microbial community by killing off beneficial bacteria along with harmful ones. This microbial imbalance, or microbiome disruption, weakens your natural defenses and allows resistant strains to flourish. When your microbiome is disrupted, harmful bacteria can overgrow, increasing the risk of recurring infections and complicating treatment. The disruption can also reduce diversity in your microbial community, making it harder for your body to recover naturally. To visualize this, consider the following:
| Healthy Microbiome | Disrupted Microbiome |
|---|---|
| Diverse bacteria | Reduced diversity |
| Balanced bacteria | Overgrowth of resistant strains |
| Strong immunity | Increased infection risk |
| Resilient community | Vulnerable to imbalance |
| Normal function | Microbial imbalance |
Understanding microbiome disruption highlights how antibiotics can inadvertently promote resistance and emphasizes the importance of maintaining microbial diversity for overall health. Additionally, research suggests that supporting microbial resilience through diet and lifestyle can help mitigate some of these adverse effects. Studies also indicate that antibiotic stewardship programs play a crucial role in reducing unnecessary antibiotic use, thereby slowing resistance development. Moreover, incorporating herbal infusions and other natural tools may aid in restoring microbial balance and supporting overall wellness. Recognizing the role of sustainable practices in healthcare can further help reduce the reliance on antibiotics and preserve their effectiveness for future generations.
Promotes Resistant Strains
As antibiotics kill harmful bacteria, they also create selective pressure that favors resistant strains. When susceptible bacteria die off, resistant strains survive and multiply, passing on their resistance genes. This process accelerates microbial evolution, as bacteria adapt quickly to the presence of antibiotics. Over time, resistant strains become more common, making infections harder to treat. Misusing or overusing antibiotics intensifies this effect, giving resistant strains an even greater advantage. Each exposure to antibiotics can select for bacteria with resistance traits, fueling a cycle of adaptation. By promoting resistant strains, antibiotics inadvertently drive the development of superbugs that threaten public health. Understanding microbial resistance mechanisms is crucial for developing effective countermeasures against resistant bacteria. Additionally, implementing antibiotic stewardship programs can significantly reduce unnecessary antibiotic use and slow resistance development.

Microbiome Labs MegaSporeBiotic Probiotics for Women & Men – Spore-Based Probiotic for Gut Health & Digestive Support – Shelf-Stable, Travel-Friendly, Mens & Womens Probiotics (60 Capsules)
100% Spore-Based Probiotic for Microbiome Support- MegaSporeBiotic uses spore-based probiotic strains to recondition the gut microbiome, promoting microbial…
As an affiliate, we earn on qualifying purchases.
As an affiliate, we earn on qualifying purchases.
How Can Vaccination and Hygiene Help Prevent Resistance?

Getting vaccinated helps prevent infections, reducing the need for antibiotics and lowering resistance risks. Practicing good hygiene limits the spread of bacteria, keeping infections from spreading to others. Understanding twin flame connections can also promote emotional well-being, which supports overall health and immune function. Additionally, maintaining a healthy lifestyle can support your immune system in fighting off infections more effectively. Embracing innovative European cloud servers can ensure secure and sustainable data management, indirectly supporting healthcare infrastructure and research efforts to combat antibiotic resistance. Incorporating water-based therapies like hydrotherapy may also aid in stress reduction and overall wellness, further strengthening immune defenses.
Vaccination Reduces Infections
Vaccination and good hygiene practices play a crucial role in preventing infections, which in turn reduces the need for antibiotics and helps slow the development of resistance. Effective vaccine development targets common pathogens, providing immunity before infection occurs. When enough people get vaccinated, herd immunity develops, making it harder for diseases to spread. This protection benefits everyone, especially those who can’t be vaccinated. By preventing infections, vaccines lessen the chances of bacteria or viruses needing antibiotics, reducing the pressure that drives resistance. Keeping infection rates low through vaccination not only saves lives but also helps preserve antibiotic effectiveness for future generations. In this way, vaccination is a powerful tool to combat antibiotic resistance and protect public health. Additionally, mammography guidelines highlight the importance of early detection in breast cancer, illustrating how preventive measures can improve health outcomes.
Good Hygiene Limits Spread
Have you ever wondered how simple hygiene practices can prevent the spread of infections? Regular hand hygiene is one of the most effective ways to stop germs from moving between people. Proper handwashing with soap and water removes bacteria and viruses, reducing the chance they’ll reach your body or others’. Surface cleaning is equally important; disinfecting frequently touched surfaces like doorknobs, phones, and countertops kills lingering pathogens. When you maintain good hygiene, you limit the opportunities for bacteria to spread and develop resistance. This not only protects you but also helps slow the rise of antibiotic-resistant infections in your community. Small actions, like washing your hands and cleaning surfaces regularly, are powerful tools in the fight against antibiotic resistance. Additionally, using air purifiers in shared spaces can help reduce airborne pathogens, further safeguarding public health. Implementing comprehensive hygiene practices in public and healthcare settings is crucial to minimizing the transmission of resistant bacteria and reducing the spread of resistant strains. Maintaining good hygiene also supports the principles of luxury craftsmanship by emphasizing attention to detail and quality in everyday practices, which can enhance overall health and resilience. Moreover, understanding the role of sound healing science in promoting well-being highlights how holistic approaches can complement hygiene efforts to improve community health.

Method Antibacterial All-Purpose Cleaner Spray, Citron, Kills 99.9% of Household Germs, 28 Fl Oz
Contains (1) 28oz spray bottle of antibacterial all-purpose cleaner.
As an affiliate, we earn on qualifying purchases.
As an affiliate, we earn on qualifying purchases.
What Is Responsible Prescribing, and Why Is It Critical?

What makes prescribing antibiotics responsible is choosing the right drug, at the right dose, for the right duration, and only when necessary. This guarantees you’re practicing appropriate use, which is crucial to slow resistance. Following prescribing guidelines helps you make informed decisions, avoiding unnecessary antibiotics for viral infections or mild illnesses that don’t require them. Responsible prescribing reduces the risk of bacteria developing resistance, preserves the effectiveness of antibiotics, and safeguards public health. It also minimizes side effects and protects vulnerable populations. Staying within established guidelines and avoiding overprescription are key steps you can take to combat antibiotic resistance effectively. Your role in responsible prescribing is essential for preserving these lifesaving drugs for future generations. Antibiotic stewardship programs play a vital role in promoting responsible prescribing practices and combating resistance on a broader scale. Implementing appropriate use strategies is fundamental in maintaining the efficacy of antibiotics over time.
What Are the Latest Innovations in Combating Resistance?

Recent advances in technology and research are opening new frontiers in the fight against antibiotic resistance. Molecular diagnostics now allow you to rapidly identify pathogens and their resistance genes, enabling targeted treatment that minimizes unnecessary antibiotic use. This precision reduces the chance of resistance development. Additionally, phage therapy is gaining traction as a promising alternative; it uses viruses that specifically target resistant bacteria, offering a personalized and effective approach. These innovations are transforming how you combat resistant infections, making treatments more precise and effective. By integrating molecular diagnostics into clinical practice and exploring phage therapy, you can stay ahead of resistant bacteria and improve patient outcomes. These cutting-edge strategies show promise in slowing resistance’s relentless progress.
How Are Policies and Global Efforts Addressing Resistance?

Global efforts and policies are essential in curbing antibiotic resistance, as coordinated action can lead to more effective containment strategies. International regulation plays a key role in setting standards, monitoring antibiotic use, and preventing the spread of resistant bacteria across borders. Countries are working together through organizations like the World Health Organization to develop action plans and share data. Global collaboration helps guarantee that efforts are not duplicated and resources are used efficiently. Policies promoting responsible antibiotic prescribing, improving infection control, and supporting research are critical. By aligning national policies with international guidelines, you can help slow resistance’s spread. These collective efforts create a united front, making it harder for resistance to outpace our ability to control it.
What Practical Steps Can I Take to Fight Antibiotic Resistance?

You can play a vital role in fighting antibiotic resistance by using antibiotics responsibly. Always follow your healthcare provider’s instructions and never request antibiotics for viral infections like colds or the flu. Practicing good hygiene, such as washing your hands regularly, reduces infection risk and minimizes the need for antibiotics. Supporting antibiotic stewardship efforts in your community helps guarantee antibiotics are used appropriately and preserved for future generations. Raising public awareness about antibiotic resistance encourages others to take responsible action and advocates for policies that promote proper antibiotic use. By staying informed and making conscious choices, you contribute to slowing resistance’s spread. Collectively, these steps help preserve antibiotics’ effectiveness and protect public health.
Frequently Asked Questions
How Does Antibiotic Resistance Affect Everyday Medical Treatments?
You’re affected by antibiotic resistance because it makes common medical treatments less effective. When resistant bacteria grow, antibiotics can’t easily kill them, leading to longer illnesses and more complications. Practicing antibiotic stewardship helps slow this. By only using antibiotics when necessary and following prescribed doses, you help prevent resistant bacteria from thriving, ensuring treatments remain effective for you and others in everyday medical care.
Can Alternative Medicines Replace Antibiotics Effectively?
Sure, herbal remedies and homeopathy might sound tempting as replacements, but don’t bet on them for infections. While some swear by their efficacy, scientific evidence remains shaky. You’re better off sticking with proven antibiotics when needed, because relying solely on herbal remedies isn’t a magic cure. Think of alternative medicines as supportive, but not primary, options—definitely not the superheroes that will save you from bacterial villains.
What Role Do Livestock Farming Practices Play in Resistance?
Livestock farming practices impact antibiotic resistance considerably. Excessive livestock antibiotic use, especially when antibiotics are given for growth promotion or disease prevention, accelerates resistance development. You can help by supporting farms that implement responsible practices, such as reducing antibiotic use and improving hygiene. Better farming practices impact resistance by limiting unnecessary antibiotic exposure, which slows down resistant bacteria spread. Your choices can encourage sustainable agriculture that prioritizes animal health without contributing to resistance.
How Does Antibiotic Use in Aquaculture Impact Resistance?
You should know that antibiotic use in aquaculture, especially in fish farms, can promote resistance spread. When antibiotics are used excessively or improperly, resistant bacteria develop in the water and fish. These bacteria can transfer to other aquatic animals, humans, or the environment, making infections harder to treat. Consequently, controlling antibiotic use in fish farms is vital to slowing resistance spread and protecting both aquatic life and public health.
Are There Specific Populations More at Risk of Resistant Infections?
You’re most at risk if you’re part of vulnerable populations facing socioeconomic challenges. Imagine crowded clinics where infection spreads easily or communities with limited access to healthcare and clean water. These population vulnerabilities make resistant infections harder to treat and more dangerous. Socioeconomic factors, like poverty and lack of education, further increase your chances of facing resistant infections, emphasizing the need for targeted efforts to protect those most at risk.
Conclusion
To truly turn the tide against antibiotic resistance, you’re the anchor in this storm. By practicing responsible use, staying informed, and supporting global efforts, you can help slow its relentless march. Think of resistance as a wildfire—you hold the extinguisher. Every small action you take is a spark that can either feed or quench the flames. Together, we can navigate toward a future where antibiotics stay strong and effective.